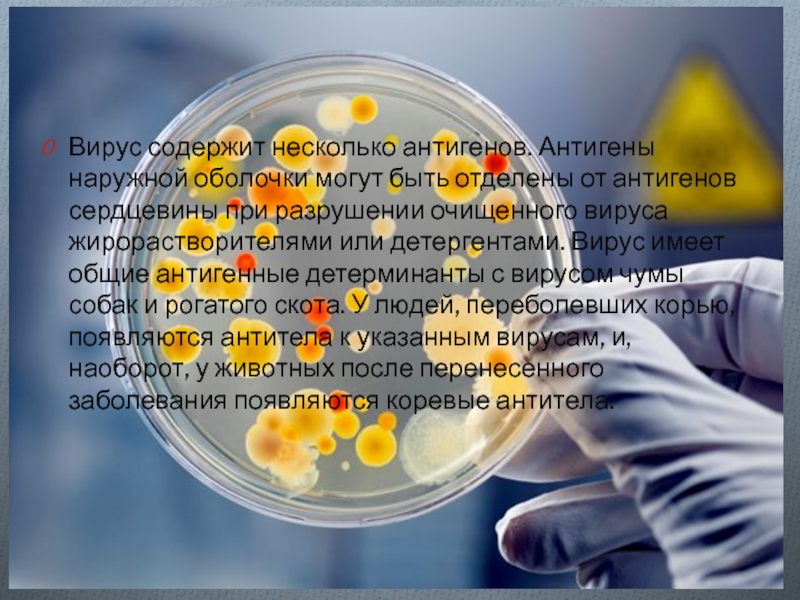

Работу выполнила:
Шогенова Заира Ж.
- Главная
- Разное
- Дизайн
- Бизнес и предпринимательство
- Аналитика
- Образование
- Развлечения
- Красота и здоровье
- Финансы
- Государство
- Путешествия
- Спорт
- Недвижимость
- Армия
- Графика
- Культурология
- Еда и кулинария
- Лингвистика
- Английский язык
- Астрономия
- Алгебра
- Биология
- География
- Детские презентации
- Информатика
- История
- Литература
- Маркетинг
- Математика
- Медицина
- Менеджмент
- Музыка
- МХК
- Немецкий язык
- ОБЖ
- Обществознание
- Окружающий мир
- Педагогика
- Русский язык
- Технология
- Физика
- Философия
- Химия
- Шаблоны, картинки для презентаций
- Экология
- Экономика
- Юриспруденция
Парамиксовирусы. Виды парамиксовирусов презентация
Содержание
- 1. Парамиксовирусы. Виды парамиксовирусов
- 2. Парамиксовирусы. Парамиксови́русы (Paramyxoviridae) — семейство вирусов, вызывающих
- 3. Морфология Вирусы имеют сферическую форму с
- 5. Геном вируса представлен однонитчатой «минус-нитевой» РНК.
- 6. Репродукция
- 7. Виды парамиксовирусов Вирусы парагриппа Вирусы паротита Вирус кори Респираторно - синцитиальный вирус
- 8. ВИРУСЫ ПАРАГРИППА ЧЕЛОВЕКА (ВПГЧ) Вирусы были
- 9. В настоящее время известно 4 типа вирусов
- 10. Патогенез Воротами инфекции являются слизистые оболочки респираторного
- 11. Клиническая картина У большинства больных парагрипп протекает
- 12. Осложнения Наиболее частым осложнением как у детей,
- 13. Вирусы паротита Эпидемический паротит (лат. parotitis
- 14. Патогенез Наиболее восприимчивы дети от 5 до
- 15. Примерно у 20% мальчиков старше 13 лет
- 16. Клиника. Инкубационный период длится 18—21 день. Болезнь
- 17. Иммунитет.
- 18. Поскольку эпидемический паротит
- 19. Вирус кори Морфология вируса кори типична
- 20. Вирус содержит несколько антигенов. Антигены наружной оболочки
- 21. Патогенез Вирус
- 22. Клиническая картина Инкубационный период составляет около 10
- 23. Температура держится 7—8 дней. Осложнением кори является
- 24. Иммунитет После перенесенного заболевания остается прочный (пожизненный)
- 25. Профилактика Профилактика основана на иммунизации живой вакциной,
- 26. Респираторно - синцитиальный вирус РЕСПИРАТОРНО-СИНЦИТИАЛЬНЫЙ ВИРУС (РС-ВИРУС)
- 27. Этиология Возбудитель - РНК-геномный вирус рода Pneumovirus
- 28. Патогенез При аэрогенном поступлении в организм человека
- 29. Клиника Инкубационный период варьирует от нескольких дней
- 30. При осмотре больных отмечают слабую или умеренную
- 31. Осложнения Осложнения связаны с активацией собственной бактериальной
- 32. Лечение Неосложнённые случаи лечат на дому, применяя
Слайд 2Парамиксовирусы.
Парамиксови́русы (Paramyxoviridae) — семейство вирусов, вызывающих корь, эпидемический паротит (свинку), парагрипп,
болезнь Ньюкасла, чумку у собак. Возможно, вызывают атипичную пневмонию.
Слайд 3Морфология
Вирусы имеют сферическую форму с диаметром 150—200 нм. Это наиболее
крупные из РНК-содержащих вирусов. Внутренний компонент представлен нуклеокапсидом, имеющим спиральную симметрию. В нуклеокапсиде содержится 2400— 2800 белковых субъединиц. Нуклеокапсид окружен липопротеидной оболочкой, которая покрыта шипиками, образованными двумя гликопротеидами вируса, HN (гемагглютинин и нейраминидаза) и F (белок слияния).
Слайд 5
Геном вируса представлен однонитчатой «минус-нитевой» РНК. РНК не обладает инфекционной активностью.
Ее молекулярная масса 5,2 •106 —5,6 • 106, среди РНК-содержащих вирусов это наиболее крупные размеры генома. Геном имеет 6 генов, расположенных в следующем порядке: 3'-NP-P/C-M-F-HN-L-5'. Ген Р/С кодирует два уникальных белка: структурный Р и неструктурный С.
Слайд 6Репродукция
Адсорбция вирусной частицы на клетке осуществляется в результате взаимодействия гликопротеида HN
со специфическими рецепторами клетки, которыми являются гликопротеиды и ганглиозиды. Вирус проникает в цитоплазму путем слияния вирусной мембраны с плазматической мембраной клетки или стенкой эндоцитарной вакуоли. Репродукция происходит в цитоплазме.
Слайд 7Виды парамиксовирусов
Вирусы парагриппа
Вирусы паротита
Вирус кори
Респираторно - синцитиальный вирус
Слайд 8ВИРУСЫ ПАРАГРИППА ЧЕЛОВЕКА (ВПГЧ)
Вирусы были выделены в 1956—1958 гг. в США
путем заражения культур клеток почки обезьяны смывами из носоглотки у детей с гриппоподобными заболеваниями. Вирусы выявляли по Р.Гадс, и первоначально они были названы гемадсорбирующими вирусами.
Парагрипп (paragrip - англ., paragrippe - франц.) - острое респираторное вирусное заболевание, характеризующееся умеренно выраженной общей интоксикацией, поражением верхних дыхательных путей, преимущественно гортани.
Парагрипп (paragrip - англ., paragrippe - франц.) - острое респираторное вирусное заболевание, характеризующееся умеренно выраженной общей интоксикацией, поражением верхних дыхательных путей, преимущественно гортани.
Слайд 9В настоящее время известно 4 типа вирусов парагриппа, выделенных от человека.
Парагриппозные вирусы агглютинируют эритроциты человека , кур, морских свинок, обезьян. Вирусы нестойки во внешней среде, при комнатной температуре сохраняются не более 4 ч, а полная их инактивация происходит после 30-минутного прогревания при температуре 50°С.
Слайд 10Патогенез
Воротами инфекции являются слизистые оболочки респираторного тракта, особенно носа и гортани,
где возникают выраженные воспалительные изменения. Парагриппозные вирусы репродуцируются в клетках эпителия дыхательных путей, разрушая при этом сами клетки. Размножившиеся вирусы и продукты распада эпителиальных клеток частично проникают в кровь, способствуя развитию лихорадки и других симптомов интоксикации, которая при парагриппе слабо выражена.
Слайд 11Клиническая картина
У большинства больных парагрипп протекает как кратковременное заболевание (не более
3-6 дней), без выраженной общей интоксикации. Заболевание возникает остро лишь у половины больных, у остальных оно начинается исподволь, из-за чего больные не всегда обращаются за медицинской помощью в первый день болезни. Беспокоит субфебрильная температура тела, общая слабость, головная боль. В клинической картине преобладают признаки поражения верхних отделов респираторного тракта. Частыми проявлениями парагриппа являются боли и першение в горле, заложенность носа, сухой кашель, симптомы ринофарингита.
Слайд 12Осложнения
Наиболее частым осложнением как у детей, так и у взрослых является
пневмония. С ее появлением процесс приобретает остролихорадочный характер со значительным повышением температуры, ознобом, сильной головной болью, болями в груди, усиленным кашлем с выделением мокроты, иногда с примесью крови.
Слайд 13Вирусы паротита
Эпидемический паротит (лат. parotitis epidemica: свинка, заушница) — острое инфекционное заболевание,
с негнойным поражением железистых органов (слюнные железы, поджелудочная железа, семенники) и ЦНС, вызванное парамиксовирусом. Название «эпидемический паротит» считается устаревшим. Сейчас это заболевание чаще называют «паротит»
Слайд 14Патогенез
Наиболее восприимчивы дети от 5 до 15 лет. Заражение происходит воздушно-капельным
путем. Вирус перемещается из полости рта по протоку околоушной железы (стенонов проток), где происходит его репродукция. Возможно, первичная репродукция вируса происходит в эпителии слизистой оболочки верхних дыхательных путей, затем вирус поступает в кровь и разносится по всему организму, попадая в яичники, яички, поджелудочную и щитовидную железы, мозг. В неосложненных случаях происходит местное поражение тканей околоушных желез.
Слайд 15Примерно у 20% мальчиков старше 13 лет развивается орхит, который может
обусловить половую стерилизацию (стерильность). При тяжелых формах орхитов яички отечны, при пунктации обнаруживается геморрагическая жидкость, происходит дегенерация эпителия семенных канальцев. Поражения ЦНС проявляются в воспалительных реакциях, повреждении нейроглии, кровоизлиянием, демиелинизацией.
Слайд 16Клиника.
Инкубационный период длится 18—21 день. Болезнь начинается с воспаления околоушной железы,
одной или обеих, и других слюнных желез. Воспаление длится около недели и сопровождается умеренным подъемом температуры. Наиболее частыми осложнениями являются орхит, менингит, менингоэнцефалит, более редкие осложнения — полиартрит, панкреатит, нефрит, тиреоидит.
Слайд 17 Иммунитет.
Перенесенная инфекция оставляет стойкий иммунитет. Иммунитет, связанный с передачей антител
от матери к плоду, эффективен в течение первых 6 мес жизни ребенка.
Существует только один антигенный тип вируса.
Слайд 18
Поскольку эпидемический паротит является сравнительно легким заболеванием, профилактики его не является
такой необходимостью, как при полиомиелите, дифтерии и других тяжелых детских инфекциях. Применение живой вакцины показано для детей старше 1 года, а также для подростков и взрослых, не болевших ранее эпидемическим паротитом. Вакцина вводится подкожно, однократно, обычно вместе с коревой вакциной.
Слайд 19Вирус кори
Морфология вируса кори типична для парамиксовирусов. Вирус имеет липопротеидную оболочку,
в которую встроены с наружной стороны гликопротеиды — гемагглютинин, F-белок.
Слайд 20Вирус содержит несколько антигенов. Антигены наружной оболочки могут быть отделены от
антигенов сердцевины при разрушении очищенного вируса жирорастворителями или детергентами. Вирус имеет общие антигенные детерминанты с вирусом чумы собак и рогатого скота. У людей, переболевших корью, появляются антитела к указанным вирусам, и, наоборот, у животных после перенесенного заболевания появляются коревые антитела.
Слайд 21Патогенез
Вирус проникает в верхние дыхательные пути и размножается в клетках эпителия
слизистой оболочки, носоглотки, трахеи и бронхов. Он попадает в кровь и вызывает поражения эндотелия сосудов. В результате экссудации сыворотки в эндотелий капилляров эпидермиса и локального некроза клеток эндотелия появляется сыпь. В полости рта обнаруживаются пятна Коплика — Филатова — везикулы, образовавшиеся в результате некроза эндотелиальных клеток слизистой оболочки полости рта.
Слайд 22Клиническая картина
Инкубационный период составляет около 10 дней до момента повышения температуры
и 14 дней до появления сыпи. В продромальном периоде инфекция напоминает острое респираторное заболевание и протекает с симптомами поражения верхних дыхательных путей (ринит, фарингит, конъюнктивит). Диагностическим признаком являются пятна Коплика — Филатова на слизистой оболочке щек. Сыпь папулезного характера сначала появляется на коже головы (в области лба и за ушами), В затем распространяется по всему туловищу и конечностям.
Слайд 23Температура держится 7—8 дней. Осложнением кори является пневмония, в раннем периоде
заболевания отек гортани, круп.
Слайд 24Иммунитет
После перенесенного заболевания остается прочный (пожизненный) иммунитет. Вирус кори подавляет активность
Т-лимфоцитов и вызывает ослабление защитных реакций организма.
Слайд 25Профилактика
Профилактика основана на иммунизации живой вакциной, приготовленной из аттенуированных штаммов вируса.
В
нашей стране для получения вакцины используют культуру клеток фибробластов эмбрионов японских перепелов. При охвате вакцинацией 90—95% детей резко снижается заболеваемость и прекращается циркуляция вируса.
Однако вакцинированные могут тоже заболеть корью в результате ряда причин: во-первых, в результате вакцинации вакциной, потерявшей иммуногенность; во-вторых, к результате отсутствия иммунитета (иммунитет формируется у 95—97% вакцинированных). Благодаря вакцинации в ряде стран корь практически ликвидирована (например, в Чехословакии).
В очагах кори детям до 2 лет и ослабленным детям старших возрастов вводят противокоревой иммуноглобулин.
Слайд 26Респираторно - синцитиальный вирус
РЕСПИРАТОРНО-СИНЦИТИАЛЬНЫЙ ВИРУС (РС-ВИРУС) -вызывающий инфекции дыхательных путей. Респираторный
синцитиальный вирус является основной причиной инфекций нижних дыхательных путей у новорожденных и детей. От данного вируса не существует вакцины. Лечение ограничено поддерживающей терапией, возможно применение кислородной маски.
Слайд 27Этиология
Возбудитель - РНК-геномный вирус рода Pneumovirus семейства Раrаmухо-viridae. Вирус имеет поверхностный
А-антиген, вызывающий синтез нейтрализующих антител, и нуклеокапсидный В-антиген, индуцирующий образование комплементсвязывающих антител. Вирус обусловливает образование синцития, или псевдогигантских клеток, in vitro и in vivo. Вирионы инактивируются при 55 °С в течение 5 мин, при 37 °С - в течение 24 ч. Возбудитель переносит однократное замораживание при -70 °С. Вирус полностью разрушается при рН 3,0, а также при медленном замораживании. Чувствителен к действию эфира, кислот и детергентов.
Слайд 28Патогенез
При аэрогенном поступлении в организм человека респираторно-синцитиальный вирус внедряется в эпителиальные
клетки слизистой оболочки, в том числе носоглотки, провоцируя развитие воспалительного процесса. Вместе с тем, особенно у детей младшего возраста, наиболее характерно поражение нижних дыхательных путей с распространением процесса на трахею, бронхи и особенно бронхиолы и альвеолы. Вследствие репродукции вируса происходят некроз эпителиальных клеток бронхов и бронхиол, лимфоидная перибронхиальная инфильтрация.
Слайд 29Клиника
Инкубационный период варьирует от нескольких дней до 1 нед. Заболевание развивается
постепенно. В зависимости от преимущественного поражения тех или иных отделов дыхательной системы выделяют несколько клинических вариантов PC-инфекции: назофарингит, бронхит и бронхиолит, пневмонию.
У взрослых и детей старшего возраста обычно развивается назофарингит, клинически не отличимый от аналогичных состояний при других ОРВИ. На фоне субфебрильной температуры тела отмечают незначительные проявления общей интоксикации - познабливание, умеренную головную боль, слабость, несильную миалгию.
У взрослых и детей старшего возраста обычно развивается назофарингит, клинически не отличимый от аналогичных состояний при других ОРВИ. На фоне субфебрильной температуры тела отмечают незначительные проявления общей интоксикации - познабливание, умеренную головную боль, слабость, несильную миалгию.
Слайд 30При осмотре больных отмечают слабую или умеренную гиперемию слизистой оболочки носовых
ходов и задней стенки глотки, инъекцию сосудов склер, иногда увеличение шейных и подчелюстных лимфатических узлов. Нередко через несколько дней наступает выздоровление.
Слайд 31Осложнения
Осложнения связаны с активацией собственной бактериальной флоры. Наиболее частые из них
- пневмония и отит. У детей опасно развитие ложного крупа. Прогноз заболевания обычно благоприятный; при развитии пневмонии у детей грудного возраста прогноз может быть серьёзным.
Слайд 32Лечение
Неосложнённые случаи лечат на дому, применяя симптоматические средства. При невозможности быстрого
определения этиологии пневмонии (не исключено присоединение вторичной бактериальной флоры) применяют антибиотики и сульфаниламидные препараты. Астматический синдром купируют парентеральным введением эфедрина, эуфиллина, антигистаминных препаратов, в тяжёлых случаях - глюкокортикоидов.